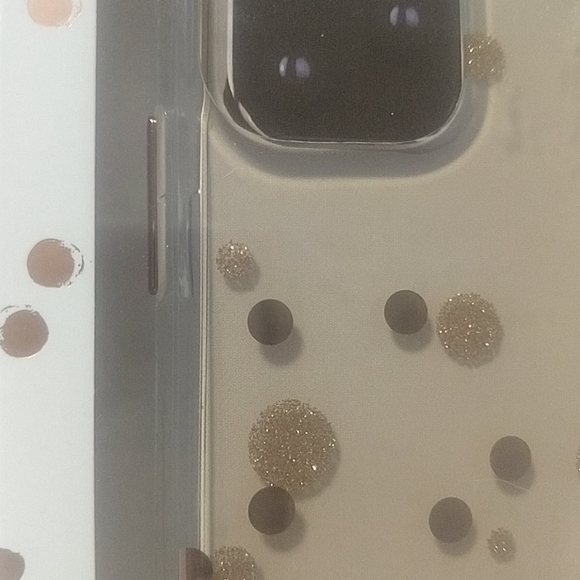
Case iPhone 11 pro - Picture 2 of 3

Case iPhone 11 pro
NWT
$8
Size
Not for sale
Like and save for later
Reduces impact on drops
Metallic button accents
Sleek profile
Hard
Shipping/Discount


pagecas
and
one other
like this
Trending Now
Find Similar Listings
Account is under Review
Comment posting is temporarily restricted. Our team will reach out to you shortly. To understand why, select
Learn More.